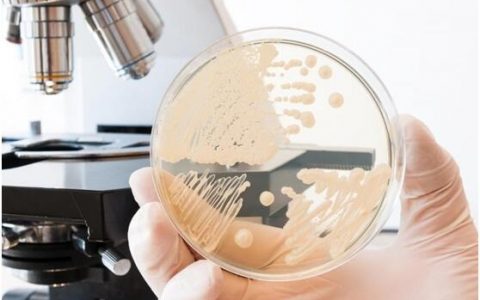
自我维持细菌电池有望在未来能源供给中发挥重要作用

【引言】 随着集成电路精度要求的不断提升,晶体管尺寸也正快速地向小型化发展。现代微电子光刻技术已逐渐满足不了日益增长的产品精度需求,传统半导体的加工工艺也几乎已...

材料牛注:“热量损失利用难,巧用新材料引围观;利用温差生电流,边做饭边把手机玩。” 犹他大学团队制作的新热电材料,无毒,高效,价格相对比较低,可收集热量,在做饭...

材料牛注:近日,新加坡国立大学研发出的一种新型纳米纤维过滤器,能有效阻隔大部分小颗粒,同时还能让空气流通,并且能在不减少自然光的条件下阻挡紫外线,应用前景广泛。...

材料牛注:自我维持细菌电池通过光养细菌和异养细菌的相互合作,实现生物能向电能源源不断的转化,有望在未来能源供给中发挥重要作用。 自我维持细菌燃料电池可能替代石油...


材料牛注:由于石墨烯优良的坚硬性、导热性及导电性,在电池,涂料等方面都有许多应用,如今石墨烯的应用又多了一种:用来做机器人的人造皮肤,甚至还有自愈功能。 石墨烯...

材料牛注:假肢对于一些伤残人士而言,必不可少,在2015年发明的更为经济的石墨烯制备的基础上,英国格拉斯哥工程大学的Dahiya课题组又为他们带来了福音——有触...

材料牛注:对于人类而言,太阳能可以算是一种取之不尽用之不竭的能源,但是由于昼夜交替以及阴晴变化等原因对其无法实现持续利用。瑞典查尔姆斯理工大学科研团队通过一种名...


材料牛注:绿色植物可以产生光合作用,为我们的生活提供氧气,但如果化石燃料消耗殆尽,谁为我们提供能源呢,别担心,别样的光合作用会再次大显身手,研究人员已经发现了一...

材料牛注:能使太空电池充分利用的电池模型也可以用到地面汽车,说不定在你汽车电量告急时救你一命哟! 这种电池模型在卫星执行任务期间,可以预测航空电池实际利用程度,...

材料牛注:近日,麻省理工大学研制出新型芯片,模拟树木结构制成“微流体泵”。此项进展有望改善微型机器人中的液压系统,实现单糖立方体为机器人供能。 如果你是New ...

材料牛注:采用特殊的材料和方法制作而成的丝绸传感器,在民用、航空和基础设施建设所用复合材料的设计研究方面将会起到很大的推动作用,并且极有可能为未来复合材料的检测...

材料牛注:科学家们成功制备了高强度的立方氮化硅,竟然是透明的!这是迄今为止最硬的透明陶瓷材料,目测要成为连阿汤哥都撞不破的窗子了!透明的立方氮化硅能够在1400...


材料牛注:富勒烯和金刚石都是碳元素的同素异形体,表现出完全不一样的物理性质。俄罗斯研究人员近日发现富勒烯在高温高压下可以形成比金刚石还硬的超硬碳材料。这一发现极...


材料牛注:科学家首次通过将异源酶嵌入真菌脂肪酸合酶的反应室,介入脂肪酸合成以生产中短链脂肪酸和甲基酮来生产可持续燃料。 科学家们研究出了可持续生产的生物燃料。瑞...

材料牛注:佐治亚理工学院的学者开发了一种纳米纤维催化剂,能有效提高电化学反应中氧析出速率。通过用钙钛矿作为催化剂的主要成分以及将催化剂制作成表面积很大的纳米纤维...